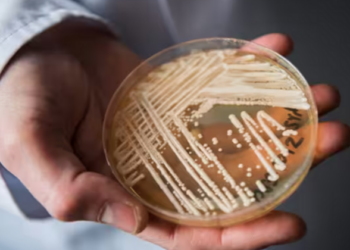
Tjetër pandemi? Zbulohet virusi i ri shumë pranë Shqipërisë, një burrë infektohet dhe ndërron jetë. Detajet

Shëndetesi
Bie vdekshmëria foshnjore/ Mjekët: Gratë shtatëzëna kanë rritur numrin e kontrolleve
Shqipëria ka regjistruar normën më të ulët të vdekshmërisë foshnjore ndër vite. Sipas të dhënave të INSTAT, në vitin 2022 ajo...
Vdekshmëria foshnjore/ Në vitin 2022 u shënua numri më i ulët, është rritur cilësia e shërbimit shëndetësor
Shqipëria ka regjistruar normën më të ulët të vdekshmërisë foshnjore. Gjatë vitit 2022 humbën jetën më pak foshnja, duke e...
Çdo minutë, 15 njerëz vdesin nga pirja e duhanit
Çdo minutë 10 milionë duhanpirës ndezin një cigare dhe 15 njerëz vdesin nga duhani. Shifrat janë bërë publike në kuadër...
Shtohen sëmundjet tumorale/ Mjekët apelojnë: Mos neglizhoni aktivitetin fizik
Sëmundjet tumorale në vendin tonë po pësojnë vetëm rritje. Në raportin e Institutit të Shëndetit Publik për kancerin e zorrës...
Zbulohet arsyeja e rritjes së rasteve me kancer në zorrën e trashë te të rinjtë
Kanceri i zorrës së trashë është një nga tumorët malinj më të diagnostikuar në botë. Megjithëse mosha mesatare e të...
Tjetër pandemi? Zbulohet virusi i ri shumë pranë Shqipërisë, një burrë infektohet dhe ndërron jetë. Detajet
Një burrë që ishte infektuar me Candida auris, e ashtuquajtura "kërpudha vrasëse" ka ndërruar jetë në Milano. Burri ishte infektuar ndërsa ishte në...
Çfarë është “Sëmundja X”? Epidemiologët japin alarmin për një pandemi të re vdekjeprurëse
Organizata Botërore e Shëndetësisë ka një listë të “viruseve prioritare” që mund të shkaktojnë pandeminë e ardhshme vdekjeprurëse. Shumica e...
Firmoset në Romë marrëveshja, Manastirliu: Dritare e re për transplantin e organeve në Shqipëri
Firmoset në Romë marrëveshja tripalëshe mes Universitetit të Mjekësisë Tiranë, Universitetit Tor Vetgata të Romës dhe Universitetit “G. D’Annunzio” të...
Ja pse pandemia e radhës mund të vijë nga Brazili
Në thellësi të pyjeve tropikale të Amazonës, shkencëtarët thonë se pandemia e ardhshme në botë mund të vijë nga kjo...
Në panik dhe të frikësuar përballë rrezikut? Ja sesi mund të qëndroni gjakftohtë
Të paralizuar nga frika. Çfarë ndodh me trupin dhe trurin tonë në një situatë të rrezikshme? Të kesh atë kthjelltësi...